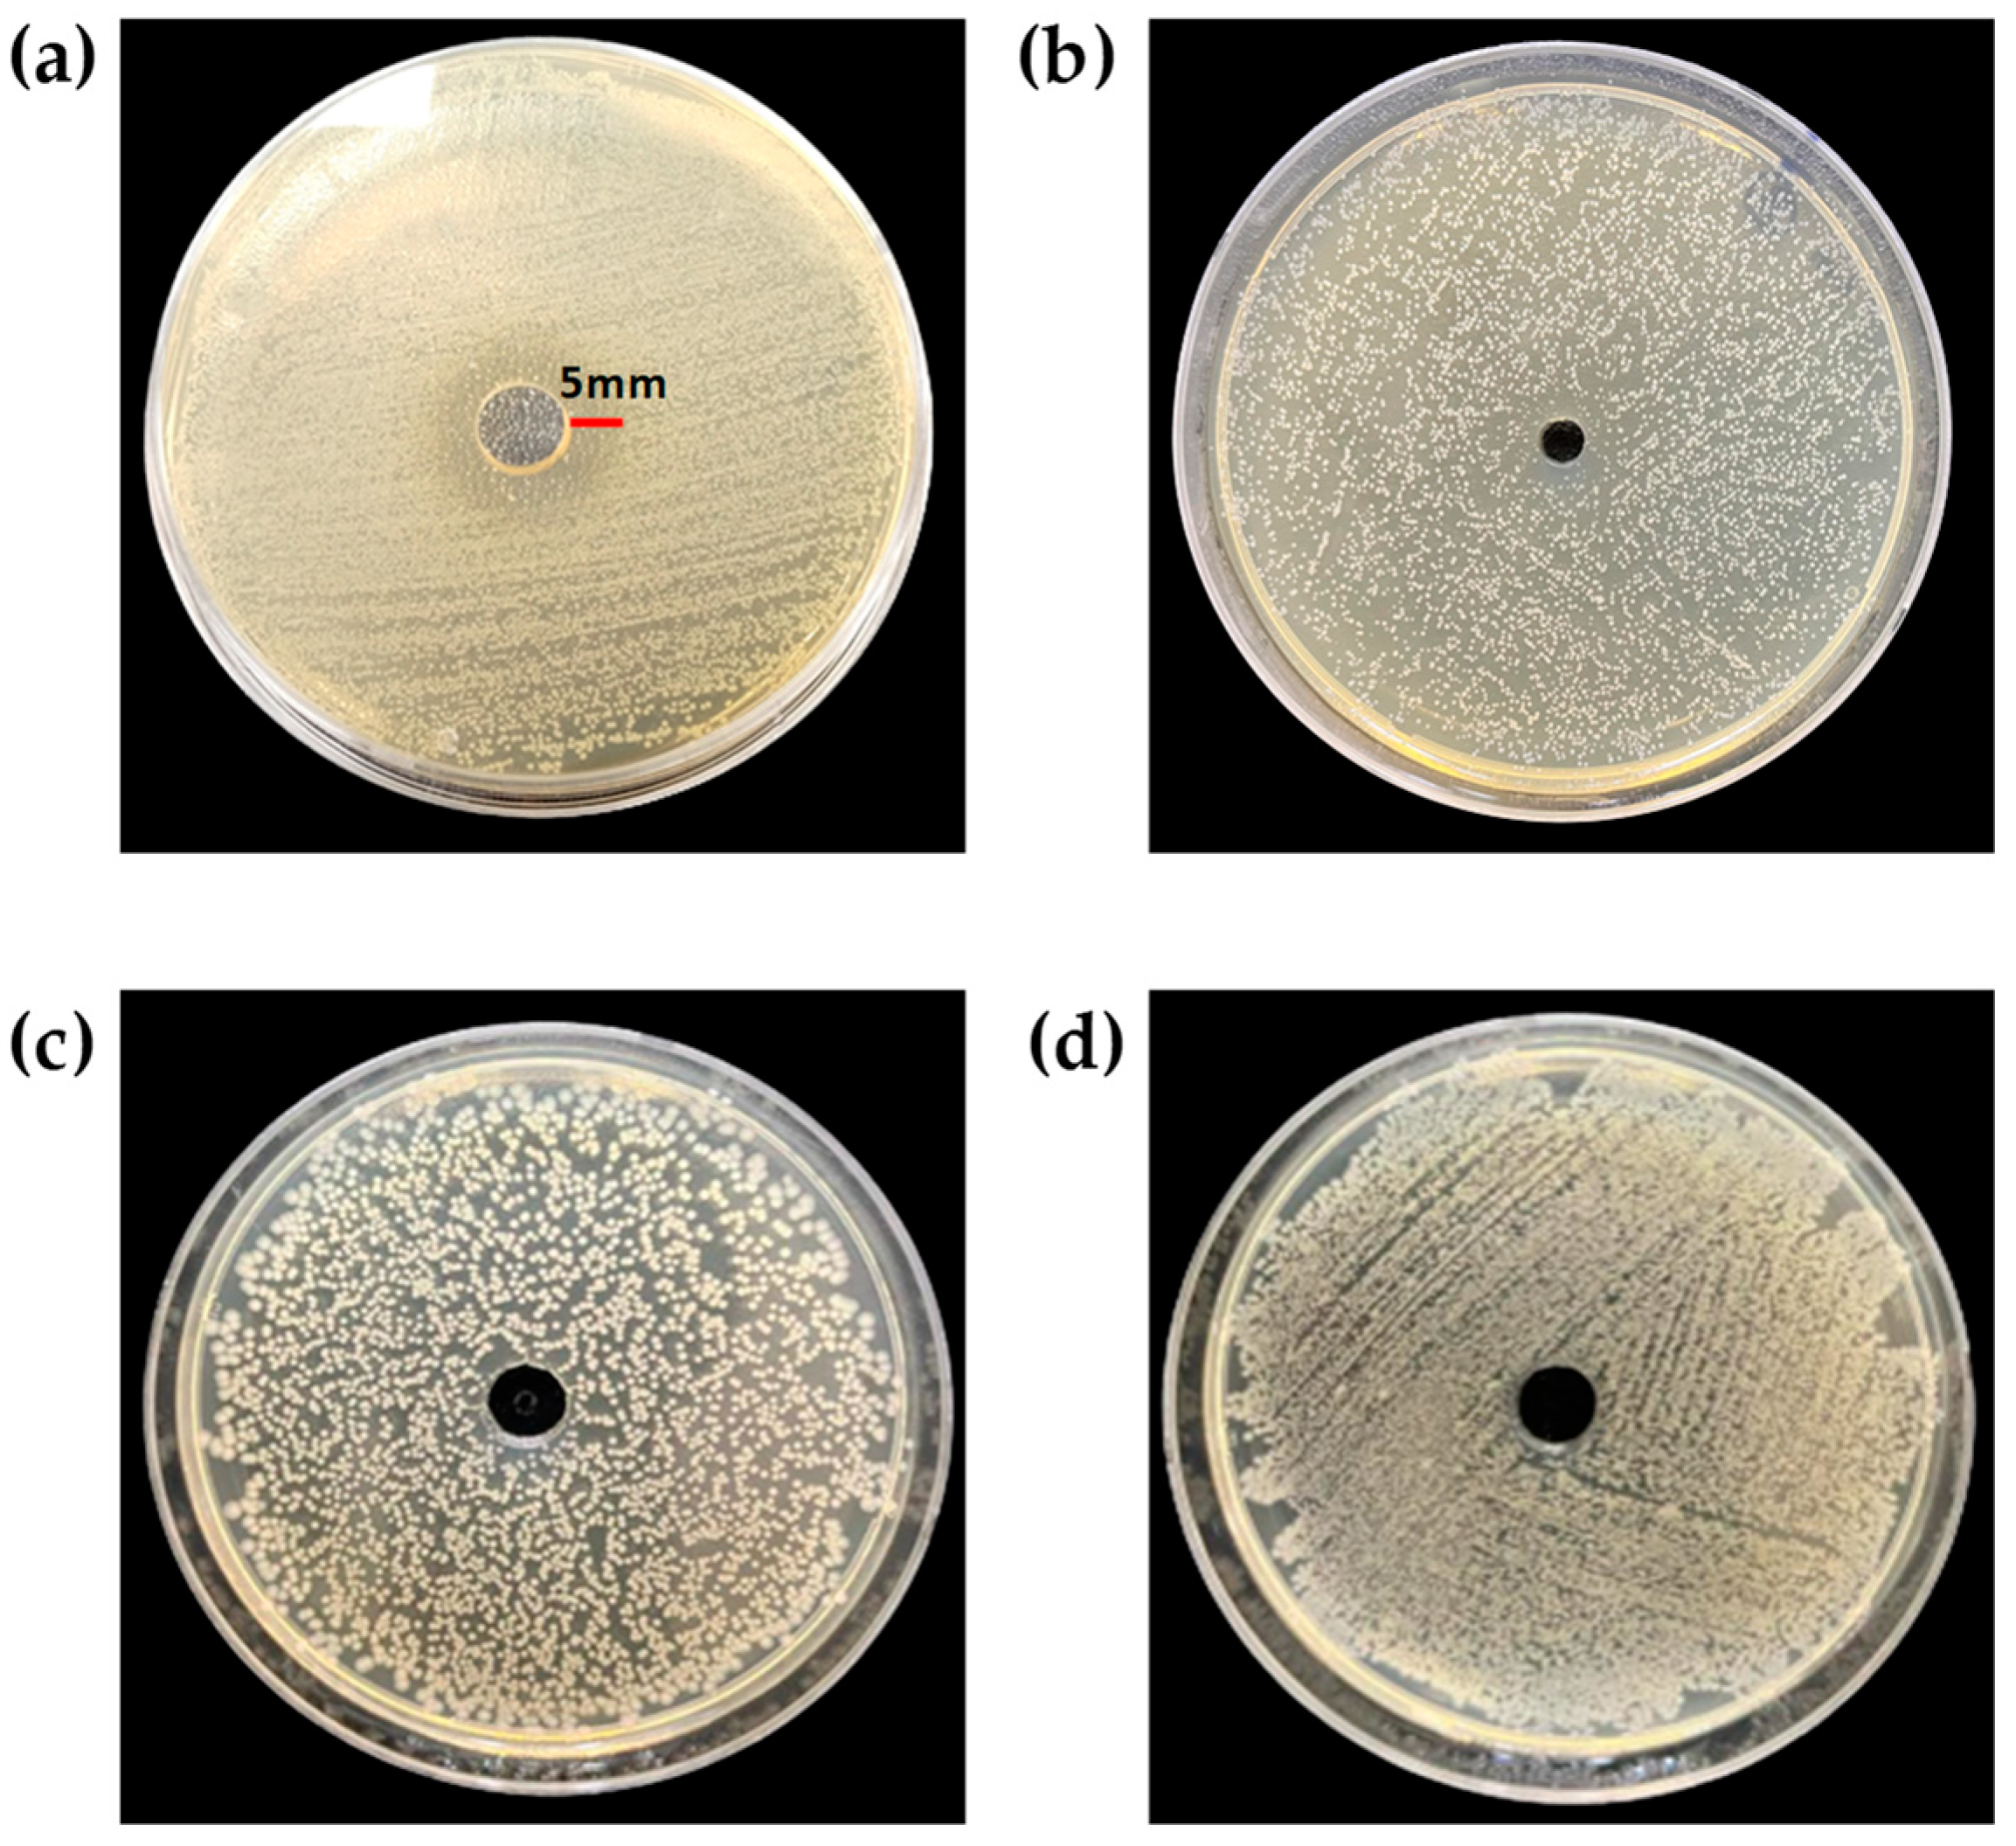
Foods 12 02165 g005

Facile Synthesis of Multifunctional Carbon Dots from Spent Gromwell Roots and Their Application as Coating Agents
Abstract
1. Introduction
2. Materials and Methods
2.1. Materials
2.2. Synthesis of g-CDs and g-SCDs
2.3. Optical and Physicochemical Properties
2.4. Antioxidant Activity of g-CDs and g-SCDs
2.5. Antibacterial Activity of g-CDs and g-SCDs
2.6. Catalytic Activity
2.7. Visual Appearance and Image Analysis of Potato Slices
2.8. Statistical Analysis
3. Results and Discussion
3.1. Optical Properties of g-CDs and g-SCDs
3.2. TEM Images and Zeta Potential of g-CDs
3.3. Antioxidant Activity of g-CDs and g-SCDs
3.4. Antibacterial Activity of g-CDs and g-SCDs
3.5. Rhodamine Dye Degradation Activity of g-CDs and g-SCDs
3.6. Visual Appearance of Potato Slice after Coating with g-CDs and g-SCDs
4. Conclusions
Author Contributions
Funding
Institutional Review Board Statement
Informed Consent Statement
Data Availability Statement
Conflicts of Interest
References
- Bhattacharya, T.; Shin, G.H.; Kim, J.T. Carbon dots: Opportunities and challenges in cancer therapy. Pharmaceutics 2023, 15, 1019. [Google Scholar] [CrossRef]
- Bello, G.L.; Bartoli, M.; Giorcelli, M.; Rovere, M.; Tagliaferro, M.A. A Review on the use of biochar derived carbon quantum dots production for sensing applications. Chemosensors 2022, 10, 117. [Google Scholar] [CrossRef]
- Xiao, P.; Ke, Y.; Lu, J.; Huang, Z.; Zhu, X.; Wei, B.; Huang, L. Photoluminescence immunoassay based on grapefruit peel-extracted carbon quantum dots encapsulated into silica nanospheres for p53 protein. Biochem. Eng. J. 2018, 139, 109–116. [Google Scholar] [CrossRef]
- Cheng, C.; Shi, Y.; Li, M.; Xing, M.; Wu, Q. Carbon quantum dots from carbonized walnut shells: Structural evolution, fluorescence characteristics, and intracellular bioimaging. Mater. Sci. Eng. C 2017, 79, 473–480. [Google Scholar] [CrossRef]
- Panda, S.; Pattnayak, B.C.; Dash, P.; Nayak, B.; Mohapatra, S. Papaya-derived carbon-dot-loaded fluorescent hydrogel for NIR-stimulated photo chemotherapy and antibacterial activity. ACS Appl. Polym. Mater. 2022, 4, 369–380. [Google Scholar] [CrossRef]
- Liu, R.; Zhang, J.; Gao, M.; Li, Z.; Chen, J.; Wu, D.; Liu, P.A. Facile microwave-hydrothermal approach towards highly photoluminescent carbon dots from goose feathers. RSC Adv. 2015, 5, 4428–4433. [Google Scholar] [CrossRef]
- Zheng, Y.; Zhang, H.; Li, W.; Liu, Y.; Zhang, X.; Liu, H.; Lei, B. Pollen derived blue fluorescent carbon dots for bio imaging and monitoring of nitrogen, phosphorus and potassium uptake in Brassica parachinensis L. RSC Adv. 2017, 7, 33459–33465. [Google Scholar] [CrossRef]
- Rojas-Valencia, O.G.; Regules-Carrasco, M.; Hernández-Fuentes, J.; Germán, C.M.R.S.; Estrada-Flores, M.; Villa, G.C.E. Synthesis of blue emissive carbon quantum dots from Hibiscus Sabdariffa flower: Surface functionalization analysis by FT-IR spectroscopy. Materialia 2021, 19, 101182. [Google Scholar] [CrossRef]
- Khan, A.; Ezati, P.; Kim, J.-T.; Rhim, J.-W. Biocompatible carbon quantum dots for intelligent sensing in food safety applications: Opportunities and sustainability. Mater. Today Sustain. 2023, 21, 100306. [Google Scholar] [CrossRef]
- Wang, J.; Qiu, J. A review of carbon dots in biological applications. J. Mater. Sci. 2016, 51, 4728–4738. [Google Scholar] [CrossRef]
- Yan, F.; Jiang, Y.; Sun, X.; Bai, Z.; Zhang, Y.; Zhou, X. Surface modification and chemical functionalization of carbon dots: A review. Microchim. Acta 2018, 185, 424. [Google Scholar] [CrossRef]
- Tuerhong, M.; Xu, Y.; Yin, X.B. Review on carbon dots and their applications. Chin. J. Anal. Chem. 2017, 45, 139–150. [Google Scholar] [CrossRef]
- Li, J.; Yang, S.; Deng, Y.; Chai, P.; Yang, Y.; He, X.; Xie, X.; Kang, Z.; Ding, G.; Zhou, H.; et al. Emancipating target-functionalized carbon dots from autophagy vesicles for a novel visualized tumor therapy. Adv. Funct. Mater. 2018, 28, 30. [Google Scholar] [CrossRef]
- Bing, W.; Sun, H.; Yan, Z.; Ren, J.; Qu, X. Programmed bacteria death induced by carbon dots with different surface charge. Small 2016, 12, 4713–4718. [Google Scholar] [CrossRef] [PubMed]
- Shen, J.; Li, Y.; Su, Y.; Zhu, Y.; Jiang, H.; Yang, X.; Li, C. Photoluminescent carbon-nitrogen quantum dots as efficient electrocatalysts for oxygen reduction. Nanoscale 2015, 7, 2003–2008. [Google Scholar] [CrossRef]
- Chatzimitakos, T.G.; Kasouni, A.I.; Troganis, A.N.; Stalikas, C.D. Carbonization of human fingernails: Toward the sustainable production of multifunctional nitrogen and sulfur codoped carbon nanodots with highly luminescent probing and cell proliferative/migration properties. ACS Appl. Mater. Interfaces 2018, 10, 16024–16032. [Google Scholar] [CrossRef] [PubMed]
- Cho, H.R.; Cho, Y.; Kim, J.; Seo, D.B.; Kim, S.H.; Lee, S.J.; Kim, N.I. The effect of gromwell (Lithospermum erythrorhizon) extract on the stratum corneum hydration and ceramides content in atopic dermatitis patients. Ann. Dermatol. 2008, 20, 56–66. [Google Scholar] [CrossRef] [PubMed]
- Roy, S.; Ezati, P.; Biswas, D.; Rhim, J.W. Shikonin functionalized packaging film for monitoring the freshness of shrimp. Materials 2022, 15, 6615. [Google Scholar] [CrossRef] [PubMed]
- Huang, X.Y.; Fu, H.L.; Tang, H.Q.; Yin, Z.Q.; Zhang, W.; Shu, G.; Yin, L.Z.; Zhao, L.; Yan, X.R.; Lin, J.C. Optimization extraction of shikonin using ultrasound-assisted response surface methodology and antibacterial studies. Evid.-Based Complement Alternat. Med. 2020, 2020, 1208617. [Google Scholar] [CrossRef]
- Roy, S.; Rhim, J. Fabrication of cellulose nanofiber-based functional color indicator film incorporated with shikonin extracted from Lithospermum erythrorhizon root. Food Hydrocoll. 2021, 114, 106566. [Google Scholar] [CrossRef]
- Arul, V.; Edison, T.N.J.I.; Lee, Y.R.; Sethuraman, M.G. Biological and catalytic applications of green synthesized fluorescent N-doped carbon dots using Hylocereus undatus. J. Photochem. Photobiol. B 2017, 168, 142–148. [Google Scholar] [CrossRef]
- Carpentier, G.; Brendt, S.; Ferratge, S.; Rasband, W.; Cuendt, M.; Uzan, G.; Albanese, P. Angiogenesis analyzer for ImageJ—A comparative morphometric analysis of endothelial tube formation assay and fibrin bead assay. Sci. Rep. 2020, 10, 11568. [Google Scholar] [CrossRef] [PubMed]
- Lunadei, L.; Galleguillos, P.; Diezmaa, B.; Lleóc, L.; Ruiz-Garcia, L. A multispectral vision system to evaluate enzymatic browning in fresh-cut apple slices. Postharvest Biol. Technol. 2011, 60, 225–234. [Google Scholar] [CrossRef]
- Roy, S.; Ezati, P.; Rhim, J.-W.; Molaei, R. Preparation of turmeric-derived sulfur-functionalized carbon dots: Antibacterial and antioxidant activity. J. Mater. Sci. 2022, 57, 2941–2952. [Google Scholar] [CrossRef]
- González-González, R.B.; González, L.T.; Madou, M.; Leyva-Porras, C.; Martinez-Chapa, S.O.; Mendoza, A. Synthesis, purification, and characterization of carbon dots from non-activated and activated pyrolytic carbon black. Nanomaterials 2022, 12, 3. [Google Scholar] [CrossRef] [PubMed]
- Marković, Z.M.; Labudová, M.; Danko, M.; Matijašević, D.; Mičušík, M.; Nádaždy, V.; Kováčová, M.; Kleinová, A.; Špitalský, Z.; Pavlović, V.; et al. Highly efficient antioxidant F- and Cl-doped carbon quantum dots for bioimaging. ACS Sustain. Chem. Eng. 2020, 8, 16327–16338. [Google Scholar] [CrossRef]
- Nasseri, M.A.; Keshtkar, H.; Kazemnejadi, M.; Allahresani, A. Phytochemical properties and antioxidant activity of Echinops persicus plant extract: Green synthesis of carbon quantum dots from the plant extract. SN Appl. Sci. 2020, 2, 670. [Google Scholar] [CrossRef]
- Moualek, I.; Aiche, G.I.; Guechaoui, N.M.; Lahcene, S.; Houali, K. Antioxidant and anti-inflammatory activities of Arbutus unedo aqueous extract. Asian Pac. J. Trop. Biomed. 2016, 6, 937–944. [Google Scholar] [CrossRef]
- Nabi, M.; Zargar, M.I.; Tabassum, N.; Ganai, B.A.; Wani, S.U.D.; Alshehri, S.; Alam, P.; Shakeel, F. Phytochemical Profiling and Antibacterial Activity of Methanol Leaf Extract of Skimmia anquetilia. Plants 2022, 11, 1667. [Google Scholar] [CrossRef]
- Pandey, A.K.; Bankoti, K.; Kumar, T.; Dhara, S. Hydrothermal synthesis of clove bud-derived multifunctional carbon dots passivated with PVP-Antioxidant, catalysis, and cellular imaging applications. BioRxiv 2022, 1–33. [Google Scholar] [CrossRef]
- Mejing, L.; Xiaoliang, H.; Shujuan, D.; Shaoyan, W.; Yong, W.; Hao, Z. Preparation of Fluorescent carbon dots from Chinese Herbal Alisma and its potential applications in photocatalytic degradation of malachite green and cell imaging. Chem. Res. Chin. Univ. 2023, 39, 234–239. [Google Scholar]
- Gvozdenko, A.A.; Siddiqui, S.A.; Blinov, A.V.; Golik, A.B.; Nagdalian, A.A.; Maglakelidze, D.G.; Statsenko, E.N.; Pirogov, M.A.; Blinova, A.A.; Sizonenko, M.N.; et al. Synthesis of CuO nanoparticles stabilized with gelatin for potential use in food packaging applications. Sci. Rep. 2022, 12, 12843. [Google Scholar] [CrossRef] [PubMed]
- Zambrano-Zaragoza, M.L.; Mercado-Silva, E.; Del Real, L.A.; Gutiérrez-Cortez, E.; Cornejo-Villegas, M.A.; Quintanar-Guerrero, D. The effect of nano-coatings with α-tocopherol and xanthan gum on shelf-life and browning index of fresh-cut “Red Delicious” apples. Innov. Food Sci. Emerg. Technol. 2014, 22, 188–197. [Google Scholar] [CrossRef]

Disclaimer/Publisher’s Note: The statements, opinions and data contained in all publications are solely those of the individual author(s) and contributor(s) and not of MDPI and/or the editor(s). MDPI and/or the editor(s) disclaim responsibility for any injury to people or property resulting from any ideas, methods, instructions or products referred to in the content. |
© 2023 by the authors. Licensee MDPI, Basel, Switzerland. This article is an open access article distributed under the terms and conditions of the Creative Commons Attribution (CC BY) license (https://creativecommons.org/licenses/by/4.0/).
Share and Cite
Bhattacharya, T.; Do, H.A.; Rhim, J.-W.; Shin, G.H.; Kim, J.T. Facile Synthesis of Multifunctional Carbon Dots from Spent Gromwell Roots and Their Application as Coating Agents. Foods 2023, 12, 2165. https://doi.org/10.3390/foods12112165
Bhattacharya T, Do HA, Rhim J-W, Shin GH, Kim JT. Facile Synthesis of Multifunctional Carbon Dots from Spent Gromwell Roots and Their Application as Coating Agents. Foods. 2023; 12(11):2165. https://doi.org/10.3390/foods12112165
Chicago/Turabian StyleBhattacharya, Tanima, Hyeon A. Do, Jong-Whan Rhim, Gye Hwa Shin, and Jun Tae Kim. 2023. "Facile Synthesis of Multifunctional Carbon Dots from Spent Gromwell Roots and Their Application as Coating Agents" Foods 12, no. 11: 2165. https://doi.org/10.3390/foods12112165
APA StyleBhattacharya, T., Do, H. A., Rhim, J.-W., Shin, G. H., & Kim, J. T. (2023). Facile Synthesis of Multifunctional Carbon Dots from Spent Gromwell Roots and Their Application as Coating Agents. Foods, 12(11), 2165. https://doi.org/10.3390/foods12112165

